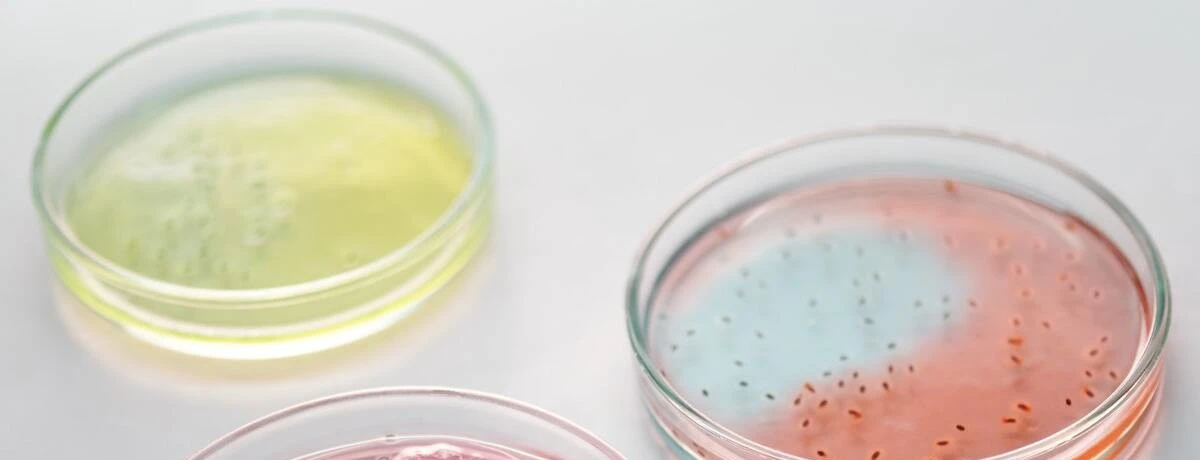

- Cos’è lo stafilococco aureo?
- Come si prende l’infezione da stafilococco?
- Cosa provoca lo stafilococco aureo?
- Che sintomi provoca?
- Diagnosi
- Come si cura l’infezione da stafilococco?
- Quanto tempo ci vuole per guarire dallo stafilococco aureo?
Cos’è lo stafilococco aureo?
↑ topLo stafilococco aureo è un batterio Gram-positivo dalla forma sferica, appartenente alla famiglia degli stafilococchi. É un tipo di batterio molto comune che fa parte della nostra flora batterica naturale. Vive infatti sulla nostra pelle e nelle nostre mucose, come il naso e la gola, e solitamente non causa alcun disturbo.
Tuttavia, quando le difese dell’organismo sono compromesse, o in presenza di ferite o lesioni, lo stafilococco aureo può diventare patogeno e causare una serie di infezioni, che possono essere localizzate o sistemiche, alcune delle quali potenzialmente letali.
La prevenzione dell’infezione comporta buone pratiche igieniche come il frequente lavaggio delle mani, la copertura di tagli e ferite e l’evitare il contatto con individui infetti.
Prenota un esame di laboratorio
Come si prende l’infezione da stafilococco?
↑ topIl contagio da stafilococco aureo avviene in genere attraverso il contatto fisico, e più frequentemente da mani contaminate. Nello specifico, la trasmissione può verificarsi attraverso:
- il contatto con oggetti contaminati come, ad esempio, maniglie delle porte, pulsanti di ascensori o attrezzi in palestra
- Il contatto diretto con un individuo infetto
- L’assunzione di alimenti o bevande contaminate
- Via aerea, mediante tosse, starnuti, gocce di saliva.
La pelle e le mucose agiscono come una barriera efficace contro il microbo. Tuttavia, quando questa barriera viene compromessa da ferite, tagli o traumi, o quando il sistema immunitario è indebolito, lo stafilococco può sfruttare queste condizioni per invadere l’organismo e causare infezioni.
Anche l’uso di dispositivi medici, come i cateteri, può ulteriormente facilitare l’ingresso dei batteri, bypassando le difese naturali dell’organismo.
L’elevata adattabilità dello stafilococco aureo favorisce inoltre la diffusione di ceppi resistenti agli antibiotici. Di conseguenza, questa situazione rende i pazienti ospedalizzati, insieme agli individui immunodepressi, particolarmente vulnerabili alle infezioni.
Stafilococco e cibi da evitare
↑ topLo stafilococco aureo si annida prevalentemente in alimenti ad alto contenuto proteico e ad acqua, come carne, pollame, prodotti lattiero-caseari, uova, maionese, creme e ripieni.
Questi alimenti, se conservati a temperatura ambiente per un periodo prolungato, o se contaminati attraverso mani o utensili sporchi, offrono un terreno fertile per la proliferazione del batterio e la produzione delle sue tossine.
Cosa provoca lo stafilococco aureo?
↑ topLo stafilococco aureo è responsabile di infezioni acute che possono coinvolgere diversi distretti corporei, tra cui:
- cute
- Apparato respiratorio
- Apparato scheletrico
- Sistema nervoso centrale
- Apparato urinario.
L’infezione, più precisamente, può avvenire secondo due possibili meccanismi:
- semplice presenza del batterio e sua relativa proliferazione: il batterio si insedia nel tessuto colpito, come la pelle o le mucose, e si moltiplica localmente, provocando infezioni
- Capacità del batterio di rilasciare tossine: lo stafilococco produce sostanze tossiche che vengono rilasciate nell’organismo, causando sintomi sistemici come nausea, vomito e diarrea, tipici delle intossicazioni alimentari.
In generale, il batterio è la causa principale di infezioni di pelle e tessuti molli. Nella maggior parte dei casi, i disturbi a cui dà esito non sono gravi. Tuttavia, è possibile che si sviluppino infezioni severe, in particolare se provocate dai ceppi resistenti alla meticillina.
In base al tipo di infezione contratta e al tipo di organi e tessuti interessati dal processo infettivo, è possibile sviluppare diverse patologie, di cui le principali includono:
- alcune malattie cutanee: follicolite, foruncolosi, impetigine, orzaiolo, sindrome da shock tossico, sindrome della cute lesionata
- Alcune infezioni del tessuto connettivo, come la cellulite infettiva
- Infezioni polmonari: polmonite batterica, empiema
- Alcune patologie di ossa e articolazioni: artrite settica, borsite settica, osteomielite
- Mastite
- Endocardite batterica
- Infezioni del tratto urinario
- Meningite
- Gastroenterite (dovuta a intossicazione alimentare).
Infezione da stafilococco aureo nei bambini
↑ topA causa del loro sistema immunitario ancora in via di sviluppo, i bambini sono più suscettibili alle infezioni da stafilococco che possono manifestarsi, in particolar modo, con:
- Patologie cutanee
- Sindrome della cute ustionata, soprattutto nei primi 5 anni di vita
- Polmonite
- Batteriemia
- Osteomielite
- Artrite settica.
Che sintomi provoca?
↑ topI sintomi provocati da un’infezione da stafilococco aureo variano in base al tipo di patologia che il batterio provoca, e alla sede coinvolta.
Le infezioni cutanee si manifestano solitamente con brufoli o foruncoli infiammati e possono evolvere in impetigine, caratterizzata da croste, o in cellulite, caratterizzata da pelle gonfia e calda.
Le infezioni ossee possono provocare, a livello dell’area infetta, dolore, calore, gonfiore, arrossamento, febbre e brividi. L’endocardite è caratterizzata da sintomi simil-influenzali, come febbre, brividi, stanchezza. Nella sua forma severa, è possibile evidenziare tachicardia, dispnea, ed edema a livello degli arti.
I sintomi della polmonite includono febbre alta, tosse, brividi, dolore al petto, fame d’aria. La sindrome da shock tossico causa febbre alta, severa ipotensione, diarrea, vomito, senso di confusione. Nel caso di intossicazione alimentare, il batterio agisce attraverso il rilascio di tossine, provocando nausea, vomito, crampi addominali e diarrea.
Diagnosi
↑ topPer accertare la presenza di stafilococco aureo si ricorre in genere, oltre che all’esame obiettivo e all’anamnesi, alla coltura di campioni raccolti da mucose, fluidi, liquidi corporei o sangue.
Una volta individuata la presenza del microrganismo, l’esecuzione di un antibiogramma valuterà quale antibiotico è più efficace per debellarlo. In alcuni casi particolari, come quello di sospetta osteomielite, è possibile avvalersi di esami strumentali come radiografia, TAC, risonanza magnetica e scintigrafia ossea.
Come si cura l’infezione da stafilococco?
↑ topIl trattamento migliore per debellare il batterio è la somministrazione di antibiotici, il cui tipo varia in base alla gravità, alla sede e al ceppo batterico responsabile dell’infezione.
In presenza di ceppi resistenti agli antibiotici standard, come le penicilline, è possibile ricorre all’uso di oxacillina. Altre classi di antibiotici che possono dimostrarsi utili sono:
- Cefalosporine
- Fluorochinoloni
- Macrolidi
- Tetracicline
- Carbapenemi
- Aminoglicosidi (come gentamicina).
Per il trattamento delle infezioni dovute a stafilococchi resistenti alla meticillina (MRSA: Meticillin-Resistant Staphylococcus Aureus) è possibile avvalersi invece di:
- Peptidi ad azione antibiotica come: vancomicina, teicoplanina, daptomicina
- Linezolid, principio attivo appartenente della classe degli oxazolidinoni.
Prenota un esame di laboratorio
Quanto tempo ci vuole per guarire dallo stafilococco aureo?
↑ topI tempi di guarigione delle infezioni da stafilococco aureo variano a seconda della gravità dell’infezione e della tempestività del trattamento.
Le forme più lievi possono risolversi in pochi giorni con l’uso di antibiotici appropriati, riposo e igiene adeguata, mentre quelle più severe possono richiedere 2-3 settimane o mesi di di terapia antibiotica e, in alcuni casi, di cure intensive.